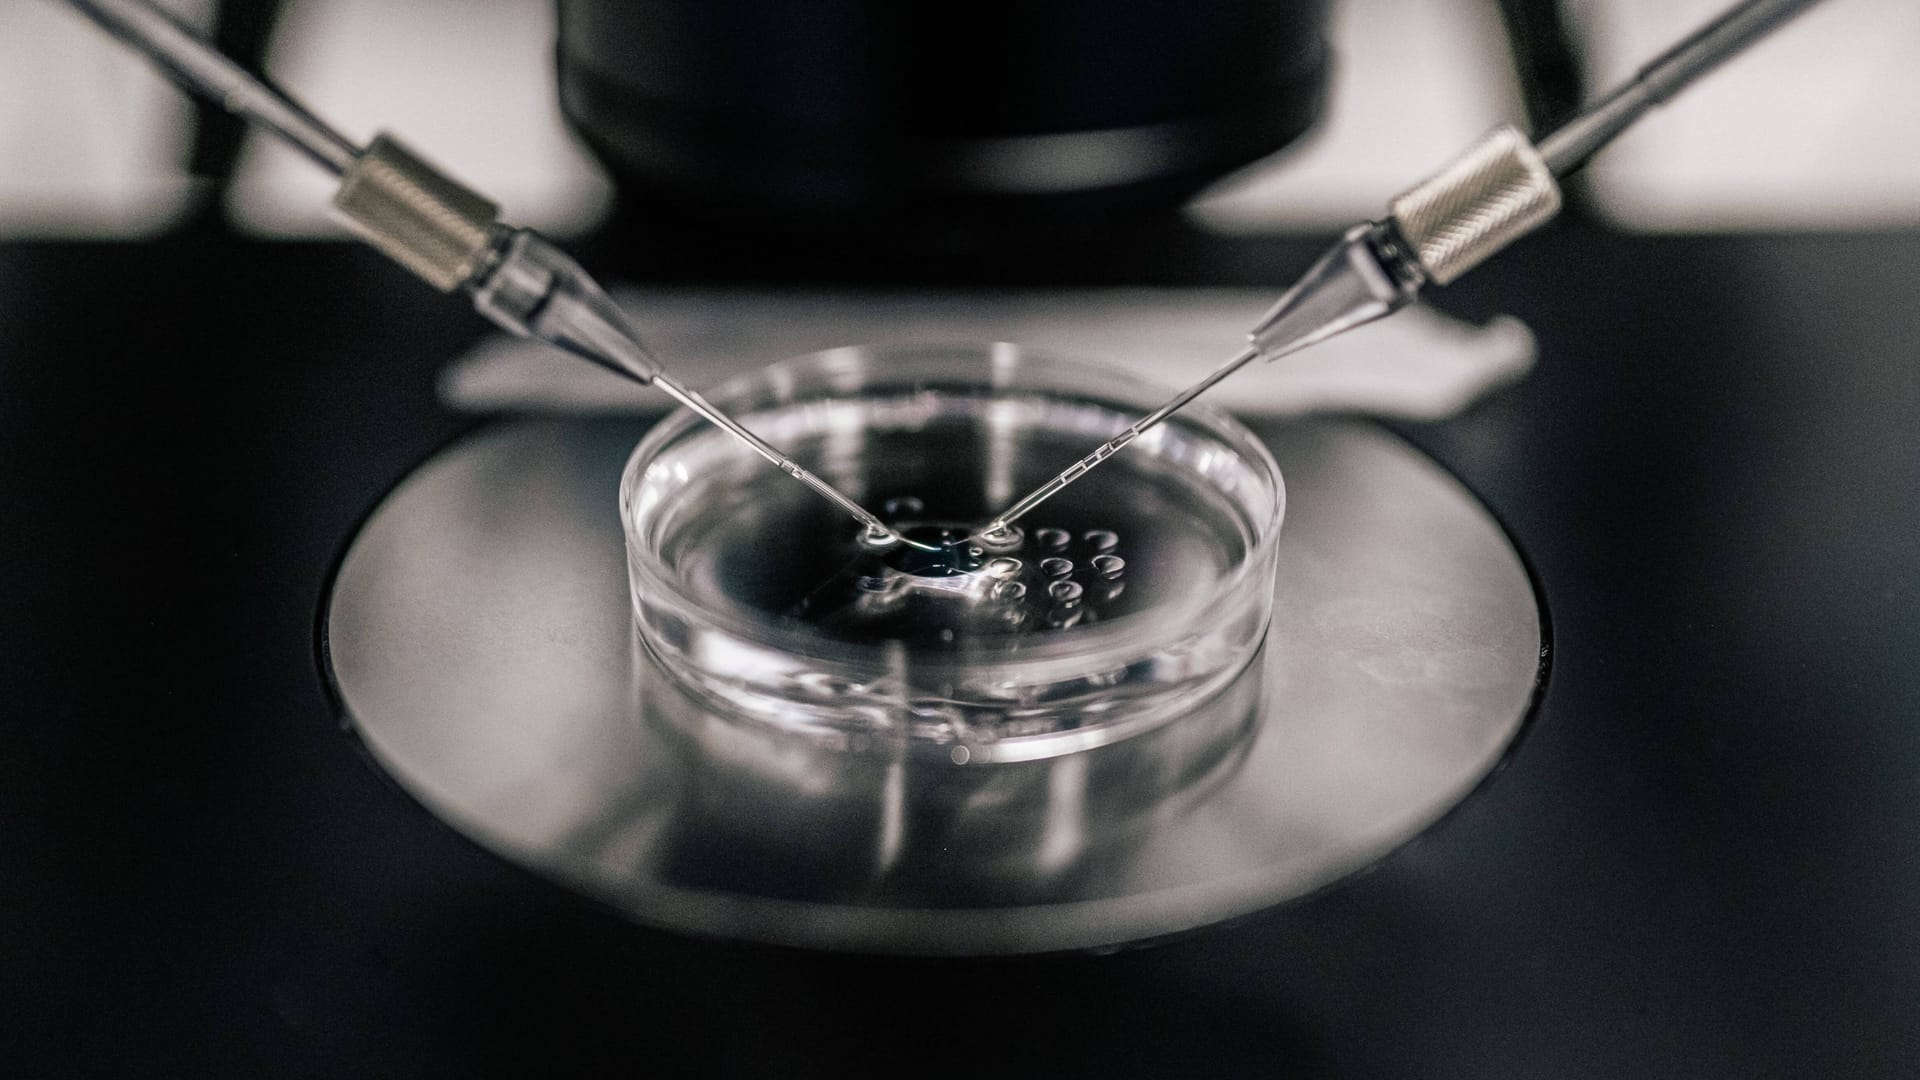

Crowdfunding-Kampagne Frau streitet mit Bonner Uniklinik um gefrorenes Sperma
Eine Frau aus dem Rhein-Sieg-Kreis streitet mit der Uniklinik Bonn um das Sperma ihres früheren Partners. Wieso die Klinik das Erbgut nicht herausgeben will.
Nach dem Krebstod ihres Lebensgefährten kämpft eine junge Frau aus Niederkassel um die Herausgabe einer Samenspende. Gegenüber dem "Kölner Stadt-Anzeiger" und auf ihrer Crowdfunding-Webseite berichtet die junge Frau, dass ihrer verstorbener Partner die Spende vor seiner ersten Chemotherapie in der Uniklinik Bonn eingelagert hatte.
Trotz einer Vollmacht, die ihr der Mann, der an den Folgen einer seltenen Krebserkrankung verstorben war, noch vor seinem Tod ausstellte, weigert sich die Bonner Klinik, die Spende herauszugeben. Ein erstes Verfahren hatte die Niederkasselerin bereits am Landgericht Bonn im vergangenen Jahr verloren – andere Verfahren von Frauen, die ebenfalls das eingefrorene Sperma ihrer verstorbenen Partner eingeklagt hatten, waren vor verschiedenen Gerichten in Deutschland bisher auch gescheitert.
Frau will mit Rechtsstreit auch für andere Betroffene kämpfen
Das Landgericht war dem "Kölner Stadt-Anzeiger" zufolge zu dem Schluss gekommen, dass die Niederkasselerin keinen Anspruch auf das Sperma ihres früheren Partners habe, weil sie dessen Vollmacht erst nach seinem Ableben bei der Klinik vorgelegt hatte.
Zudem würde sich die Klinik mit einer Herausgabe der Spermien strafbar machen, heißt es. Denn die Befruchtung mit dem Samen eines Toten ist in Deutschland verboten – allein die Übergabe an die Niederkasselerin wäre damit also eine Beihilfe zur Straftat gewesen.
Wegen dieser Gesetzeslage, dem Embryonenschutzgesetz von 1991, hatte die Niederkasselerin geplant, ihre Befruchtung von Ärzten in den Niederlanden durchführen zu lassen. Mit einer Crowdfunding-Kampagne sammelt die Niederkasselerin nun Geld für ein Revisionsverfahren: So will sich die Frau auch für andere deutsche Frauen einsetzen, die wegen der Gesetzeslage ebenfalls keine Kinder bekommen können.
Auf ihrer Crowdfunding-Website schreibt die Niederkasselerin: "Damit ein Umdenken sowie eine Modifizierung dieser veralteten Gesetzgebung stattfindet, möchte ich mein Teil dazu beitragen, um es Frauen, die sich in der selbigen Situation befinden wie ich es bin, einfacher zu machen."
- gofundme.com: "Wunschkind trotz Tod"
- gesetze-im-internet.de: Gesetz zum Schutz von Embryonen
- Kölner Stadt-Anzeiger, E-Paper, 03.04.2024
- radiobonn.de: Saskia kämpft um Gefriersperma ihres verstorbenen Freundes
- ksta.de: Bonner Klinik muss Samenspende von verstorbenem Mann nicht herausgeben